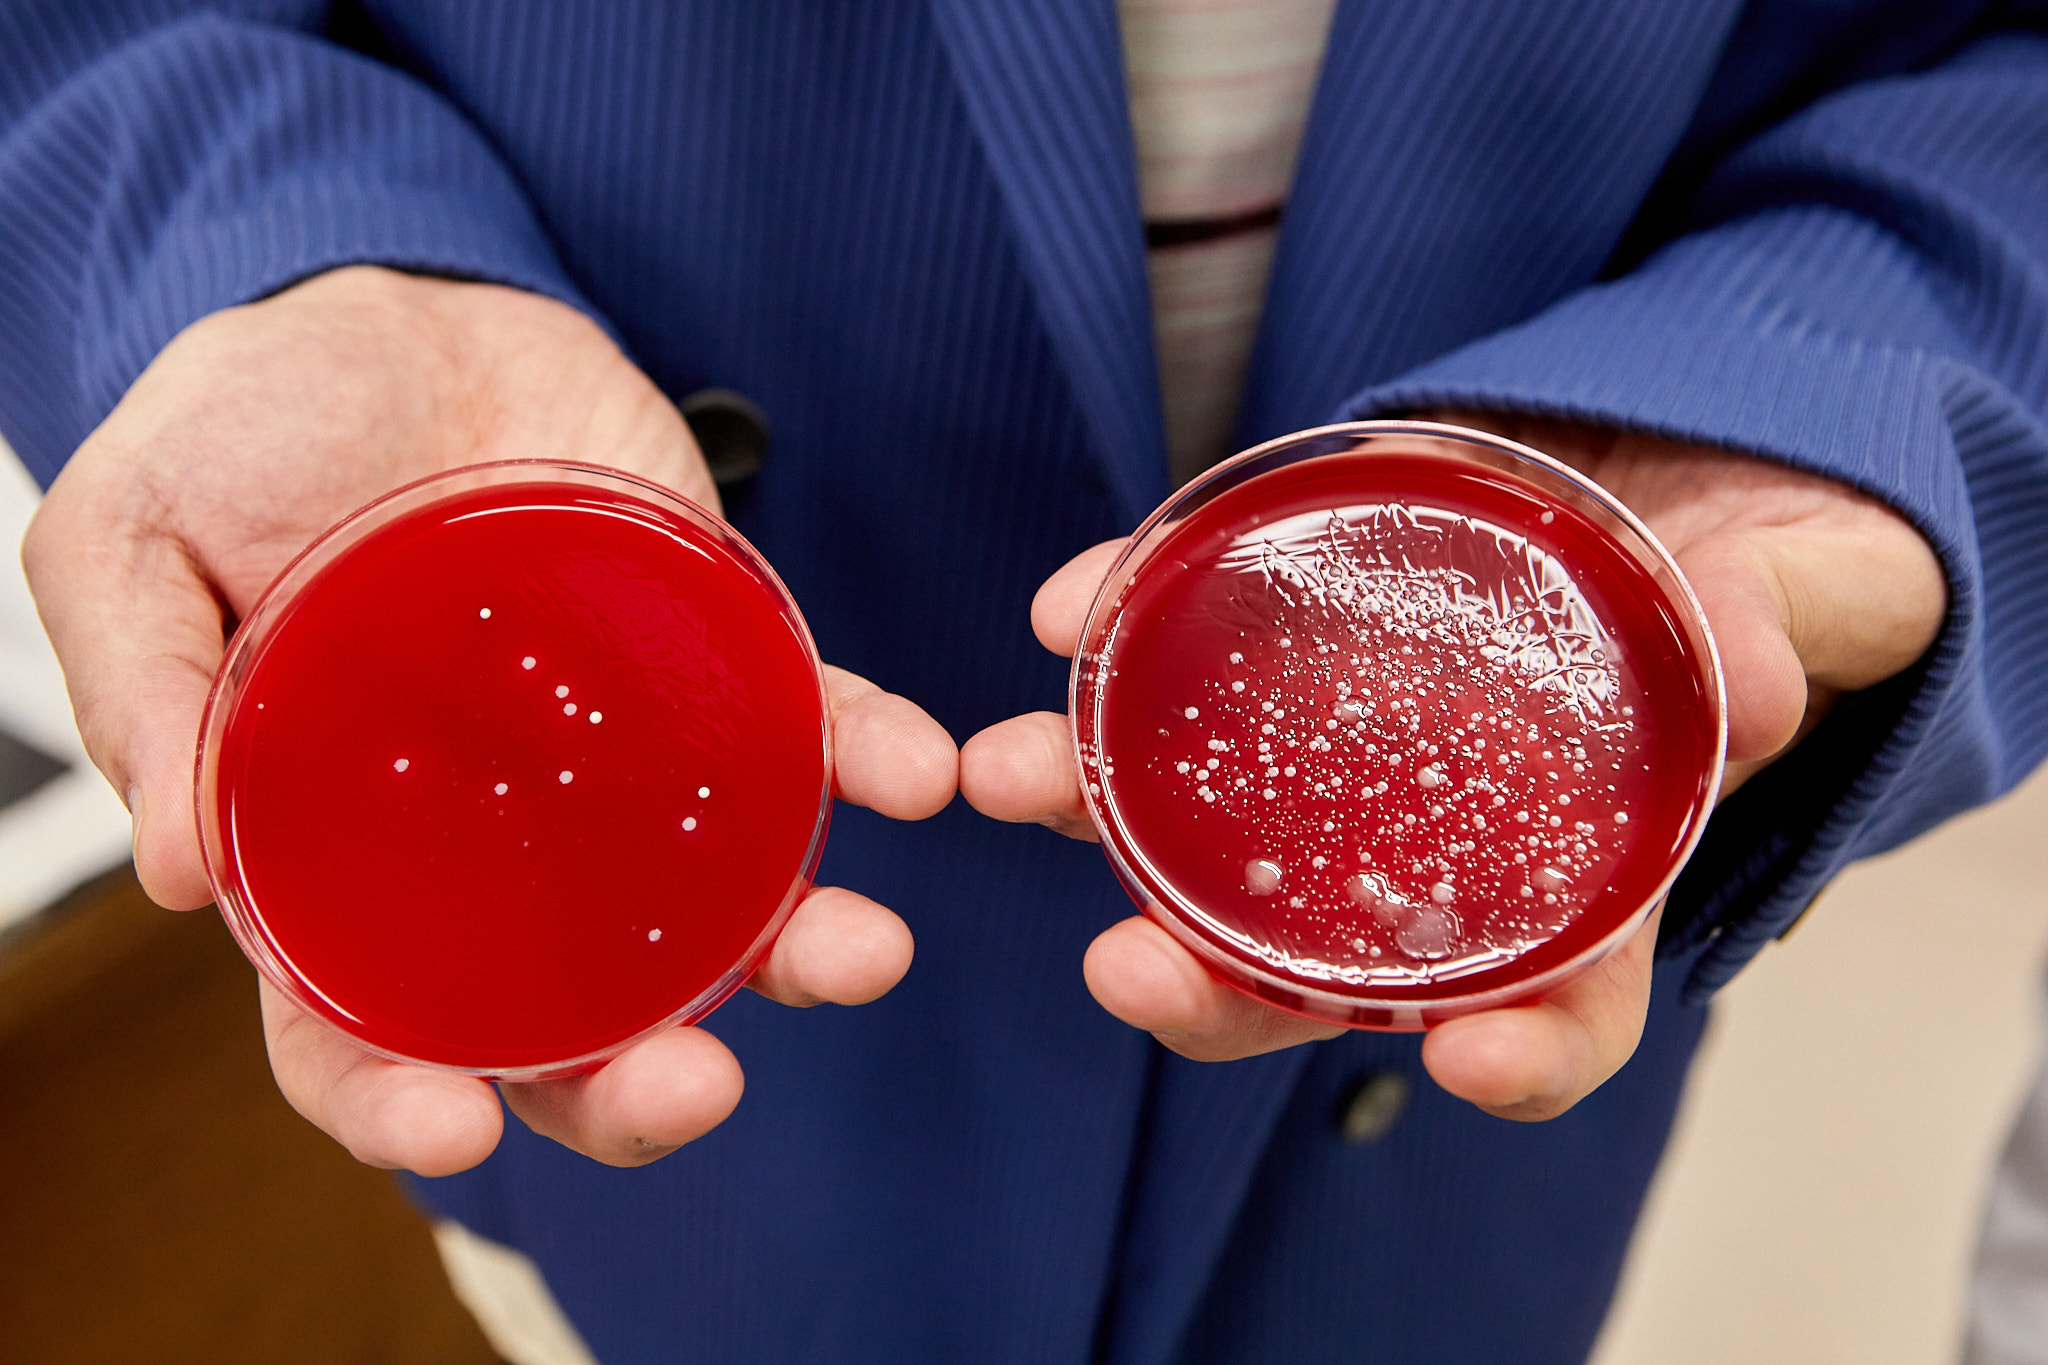

「エリエールPet キミおもい®」を共同研究 古坂大魔王さんが北里大学を訪問
記事公開:2024.1.23
上写真:北里大学獣医学部を訪れた古坂大魔王さん(右)と学部長の岡野昇三先生(岡崎健志撮影)
1943年の創業以来、衛生用紙製品、吸収体製品を中心にさまざまな商品を展開してきた大王製紙株式会社から、今年9月に誕生したのが「エリエールPet キミおもい®」(以下:「キミおもい®」)。ネコちゃん用14商品、ワンちゃん用17商品のラインナップはどれも、“ペットと、ペットと暮らす家族のより幸せな暮らし”の実現を目指し、「ペットオーナーへのやさしさ」と「ペットへのやさしさ」の二つを兼ね備えた商品として開発されました。
ペットへのやさしさを実現するために協働しているのが、北里大学獣医学部。ブランドアンバサダーを務めるお笑い芸人の古坂大魔王さんが、商品で花開いたペットへのやさしさの“種”を探しに、北里大学獣医学部を訪問しました。
先生と学生が一丸となって共同研究に取り組む
北里大学獣医学部十和田キャンパスは、青森県十和田市にあります。十和田湖にほど近く、自然豊かな環境から “大地のキャンパス”ともされています。人と動物の共生を目指す動物生命科学にもとづく高度な教育・研究をモットーとし、日々動物たちの命の輝きに触れながら、約1500人の学生がこの場所で学んでいます。

大学に到着した古坂さんを案内する岡野先生(岡崎健志撮影)
「キミおもい®」が目指す「ペットへのやさしさ」とは、ペットがより自然な状態で、健康・快適に暮らせる環境を実現すること。そのために、商品開発には言葉を話さないペットたちの、その行動や習性から彼らの思いを読み解く「動物行動学」や、彼らの感じる「感覚」の視点を取り入れています。北里大学獣医学部は、「キミおもい®」の商品開発者たちがペットについて深く理解し、確信を持ってペットにやさしい商品を届けられるよう、動物行動学をはじめとした、商品や開発にかかわるさまざまな調査研究を行っています。
「『キミおもい®』の共同研究においては、各分野に精通する専門の先生方、そして在籍する学生たちも一緒になって調査研究を行っています。本校の理念にも通じる、 “ペットとオーナーのより幸せな暮らしのために”という『キミおもい®』のブランドコンセプトに全員が賛同し、一丸となって調査研究を進めています」と学部長の岡野昇三先生。
この日も、岡野先生を含む3人の先生と、研究に携わる複数の学生たちが古坂さんを案内してくれました。

迎えてくれたミニチュア・ホースの「ショッカー」を引きながら、学生たちに厩舎(きゅうしゃ)の案内を受ける。「厩舎に入るの何気に初めて!」と楽しそう(岡崎健志撮影)

馬の世話。蹄(ひづめ)の裏をきれいにしてもらうために馬が自ら脚を上げる様子を見て、「ちゃんとわかってる!」と感心する古坂さん(岡崎健志撮影)
各施設の紹介を受けたり、すれ違う学生と言葉を交わしたりしながら、敷地を散策した後は、いよいよ「キミおもい®」のためにどんな研究が行われたのか、その現場へと向かいます。
すべての商品が、ペットのことを考えて開発されている
「キミおもい®」の商品開発の考え方は、 “すべての商品がオーナーの使いやすさという視点だけでなく、ワンちゃんやネコちゃんにとって良いものという視点も取り入れる”こと。たとえば、ウエットティシューは大王製紙ですでに人向けの商品がありますが、人と動物では全身の毛の生え方や皮膚の厚さなど、体のつくりに違いがあります。「キミおもい®」では動物向けの専用品としての調査研究とそれに基づく開発を行い、「全身すっきりシート」「肌にやさしいウエットティシュー」として発売に至りました。
ワンちゃんの肛門周りなどを綿棒で拭き取り、採取した細菌を培養することで、商品の効果を検証。左が肌にやさしいウエットティシューで拭いた後、右が拭く前に採取したもので、体についた細菌が多く拭きとれていることがわかる(岡崎健志撮影)
どんな調査を行ったのでしょうか。
岡野先生は、「愛犬の散歩から帰った後に足を拭いたり、排泄(はいせつ)の後に肛門(こうもん)を拭いたりすることは、細菌によるトラブルからワンちゃんを守るだけでなく、菌を家の中にできるだけ持ちこまないようにすることでもあります。きっと、小さなお子さんのいる家庭などはとくに気にされる部分。ワンちゃんとの暮らしを想定し、そこにおけるエビデンスをとろうということで実施したのが拭き取り前後の細菌の採取と培養による調査でした」と話します。

ワンちゃんの足裏をシートで拭き、綿棒で菌を採取するところの見学時。培養の研究は岡野先生が船頭となって行われた(岡崎健志撮影)
さらに、ワンちゃんの皮膚の厚さは人間に比べて3分の1しかないこと、また皮膚の表面は人間とは違ってアルカリ性寄りであることなども考慮し、シート素材の肌あたりのよさや薬液成分にも気を使い、商品は開発されました。
「汚れを取るだけなら薬液をいっぱい使えばいいわけですが、それでワンちゃんの皮膚が荒れてしまっては本末転倒ですよね。この微妙な塩梅をより詳細に導き出すため、現在も研究は進行中です」
と話す岡野先生に、古坂さんの目が光ります。
「出して終わりじゃないのがいい。発売後は実際に使ったユーザーの声も届くだろうし、商品はこれからどんどんアップデートされていくっていうことですよね。それってすごくいいこと!」(古坂さん)
ワンちゃんネコちゃんの体の構造の研究、「オタクでしかないじゃないですか!」
続いて古坂さんは、ワンちゃんのおむつ「のびのび動けるアクティブウェア」や各種猫砂の開発にかかわる調査研究を統率した、北里大学獣医学部准教授・柿崎竹彦先生のもとへ。柿崎先生は、ワンちゃんやネコちゃんができるだけ自然な状態で使える商品開発のために、ワンちゃんやネコちゃんの「体の構造」を調べています。

CTスキャンの操作室で、実際に撮った画像を見せながら、商品にどう活かされたのか説明する柿崎先生(岡崎健志撮影)
まずはおむつ開発にまつわる調査についてです。「研究では、CTスキャンでさまざまな犬種、大きさのワンちゃんを撮影しました。そこから、しっぽの太さやしっぽの付け根から肛門やペニスまでの距離、臀部や胴回りのサイズなどの体型の細かな情報を集めて検証。すると、例えばワンちゃんのしっぽの太さについては、犬種や大きさだけでなく体重にも依存するということがわかったんです。ワンちゃんは人間と違って腰骨が出ていないし、活発に動くことで脱げやすくもある。それを解消するにはどうしたらいいのか、というところからこの調査研究を始めたのですが、新しいデータが蓄積され、思いがけない結果も出て、個人的にも面白いなって思いました」(柿崎先生)
この研究結果から、ずれにくい伸縮バンド構造の採用、さらにサイズ調整が自在にできるおなかまわりアジャスター、4段階の大きさ調整が可能なしっぽ穴という機能が生まれ、日本で唯一※のパンツタイプ犬おむつ「のびのび動けるアクティブウェア」の誕生に至りました。
※サイズ調整可能でお腹まわりにポケット構造ができるパンツ形状おむつとして、先行技術調査及びMintelGNPDを用いた大王製紙調べ。2023年4月。

「のびのび動けるアクティブウェア」の伸縮バンド機能を試す。「すっごい伸びる。しかもやわらか!赤ちゃんのより全然やわらかい!」(岡崎健志撮影)
「研究結果を生かした強い商品開発力で、大王製紙さんはしっぽ穴の部分でさくっと特許まで出願したんだからすごいですよ」と柿崎先生。
「えー!!そっか、なるほど!すっごぉい!!!」とひっくり返りそうになる古坂さん。
でも、まだまだ調査研究案内は続きます。次に柿崎先生が紹介したのは、ネコちゃんの肉球に関する調査研究です。

ネコちゃんの登場に、思わず顔がゆるむ。スキャナーの上におとなしく乗るネコちゃんに「うちのコマオーじゃ絶対無理!なんでそんなお利口なの?連れて帰ってい??」と古坂さん(岡崎健志撮影)
「一般家庭で飼われているネコちゃんたちにも協力してもらい、肉球のスキャンデータを集めました。肉球の構造をしっかり調べることで、どこに砂が挟まりやすいかわかると、トイレで猫砂を使うときのネコちゃんの快適さにつながっていきそうかなと思ったのがこの研究の始まりです」(柿崎先生)
スキャンデータを撮り、そこから何を調査していくかは柿崎先生のオリジナル。より砂が挟まりそうな場所はどこなのか、肉球と肉球の間の距離のデータ収集など、開発者と協力し、試行錯誤しながら研究を進めました。
「本当は、実際に肉球に砂が挟まっている状態のデータを集めたいのだけど、ネコちゃんも自分できれいにするから、データをとる研究所までつけてくることってそうそうないんですよね。なので、集まっているデータからネコちゃんの平均値にあたる肉球を3Dプリンターで作って、それで僕が砂をかいてみるのもいいのかなって今は考えています」(柿崎先生)
「模型を使って、どこに砂が挟まりやすいかを見るっていうことですか?」(古坂さん)
「そうです。こうやってね(砂をかく手ぶりをしながら)」(柿崎先生)
「……何かが生まれる可能性を感じる(笑)」(古坂さん)
「ははは、じつは3Dプリンターは、『キミおもい®』の共同研究のために買わせてもらったんですけど。またひとつ、おもちゃが増えました(笑)」(柿崎先生)

あまりに楽しそうに話す柿崎先生に、ときに目を丸くしたり、つられて大笑いしたりしていた(岡崎健志撮影)
「先生……オタクでしかないですよね、オタクじゃなきゃできないですよね(笑)。いや、それってすごいことで、さっきのCT画像でのデータ集めもそうですけど、あんなにコツコツ、好きじゃなきゃできないじゃないですか。なんか、すごい……!」(古坂さん)
実際はどうなのか、ペットが受けるストレスもしっかり検証
また、「キミおもい®」の商品は、実際にワンちゃんやネコちゃんがストレスなく使用できているかどうかの検証もされています。
たとえばワンちゃんのおむつでは、はかせるとワンちゃんが違和感から動かなくなってしまったり、嫌がって脱ごうと暴れたりすることがあります。そこで、おむつをはかせたワンちゃんのストレステストも行われています。研究を牽引したのは北里大学獣医学部准教授の松浦晶央先生と学生たち。古坂さんを案内します。

この日協力してくれたのはビーグルの「ナリ」。胸に心拍センサーを巻いている。「やっぱワンちゃんもかわいいな~」(岡崎健志撮影)
「おむつをはいていない状態とはいた状態で、心拍に違いがあるのかどうかを、2つの機器を使って調べました。一つはワンちゃんのおなかに巻いて直接心拍を計るもので、もう一つは赤外線を利用した、非接触で脈の動きや振動を確認できるもの。ワンちゃんが違和感を持ったり嫌だなと感じたりすると心拍が上がるはずなんですけど、結果的に『キミおもい®』の『アクティブウェア』でそれはなく、ワンちゃんはそんなにストレスを感じていない傾向が見られています」(松浦先生)

なんだなんだ?おむつは大丈夫だったけど、人が多くてちょっぴり緊張していたナリ(岡崎健志撮影)
愛犬におむつをはかせると、粗相の心配から解放され、ドッグカフェやホテルをはじめ、気兼ねなくワンちゃんと一緒におでかけできる場所を増やしていくことにもつながります。「キミおもい®」は、オーナー目線になりがちなワンちゃんのおむつにおいても、ワンちゃんの気持ちを置き去りにすることなく、豊かな暮らしに貢献したいという研究者や開発者の思いが込められているのです。
「飼い主さんとその愛犬がいい形でいられるのが一番いい」と古坂さん。時折深くうなずきながら、松浦先生の話に聞き入っていました。
よりポジティブに、ワンちゃんやネコちゃんが“好む”ことまで追及
さらに、「キミおもい®」のペットへのやさしさは、ワンちゃんやネコちゃんがストレスなく受け入れることだけでなく、彼らがよりポジティブに、“好む”ことも追求しています。ワンちゃんやネコちゃんの「行動評価」という研究によって実現を目指し、具体的には、ワンちゃんやネコちゃんがより好みそうな視点を取り入れるべく行った、トイレに関する行動評価です。

研究のためのセットを前に、ワンちゃんのトイレ行動評価について説明する松浦先生(岡崎健志撮影)
「散歩中に芝生の上でワンちゃんがおしっこをするシーンをイメージして、まずは人工的に作った異なる3種の芝生の香りをつけたものと、何もにおいをつけていないもの、全部で4つのトイレシートをサークル内に設置しました。それからワンちゃんにシートを設置したサークル内で過ごしてもらい、どのにおいの場所で滞在時間がもっとも長かったかを調べました。場所による好みもあるのでシートの置き位置をランダムに変えながら、1か月くらいの期間で繰り返し、10数匹のワンちゃんに協力してもらいました。その結果、ワンちゃんにとって好ましいと考えられるのが、『グラスフィール』だったんです」(松浦先生)

「たっぷり吸収パワフル消臭シート」に採用されたグラスフィール成分は、まさにこの研究によって採用が決まった(岡崎健志撮影)
とくに住宅が密集する都市部では、散歩中の愛犬の排泄によるニオイや汚れなど、近隣に迷惑をかけないようにかなり気を使います。その点、ワンちゃんにとって快適なトイレ環境を自宅につくってあげることができれば、室内で排泄するワンちゃんが増え、飼い主の心理的負担を減らすことにつながるかもしれません。そのような狙いもあり、トイレシートにワンちゃんにとって好ましい香りをつける研究がスタートしました。

グラスフィール成分が配合されたシートのにおいをかぎながら「僕にはぜんぜん(香りが)わからない」と一言。ワンちゃんが感知する嗅覚の範囲は人とは異なるためで、商品はワンちゃんが感じ取れるような香りで設計している(岡崎健志撮影)
ネコちゃんのトイレ行動評価は、素材が異なる砂を入れたトイレを2つ並べて設置し、1匹あたり1週間、砂の交換頻度にパターンを持たせながら、どちらの砂を選ぶかという検証を、学生が中心になって行いました。

5秒に1回シャッターを切れるカメラでトイレを撮影し、ネコちゃんがどちらの猫砂で排泄をしたかを割り出した。「膨大な写真から永遠と、ネコちゃんのトイレシーンを探したわけですね。すごいな~」(岡崎健志撮影)
「個体によって好みはいろいろで、この砂がベスト、というのはじつはまだ出ていません。今後はさらに、たとえば同じ素材であっても、異なる大きさや形状のものを細かく比較して、ネコちゃんにとって快適で好きな砂を導き出していけたらと考えています」(松浦先生)
「“ネコちゃんに人気の猫砂!”っていうことですね。人間だって全員が好きなものなんてないですもん。多くのネコちゃんが好きですよっていう傾向がわかっていったら、面白いですね」(古坂さん)
「キミおもい®」のペットへのやさしさの“種”は、あふれる動物への愛だった

ミニチュア・ホースのショッカーの体重は78kg、そして御年29歳(在学生より年上!)のおばあちゃん馬だ。そんなショッカーを囲んで、馬談義に花が咲いた(岡崎健志撮影)
今回の北里大学訪問中、先生とも学生ともたくさん話した古坂さん。その出会いの中にこそ、「キミおもい®」のやさしさの“種”があったと古坂さんは話してくれました。

子牛を連れた学生に声をかけ、しばし交流。古坂さんの「小さくて、顔もかわいいねえ」に、まるで返事をするように子牛が「モウ」(岡崎健志撮影)
「動物たちに接する学生たちの視線が、我が子を愛する親の目線じゃないですか。その感じが、やさしさだよなって。学生も先生も、動物への愛にあふれてる。それがなければ動物のことなんて知れないし、それこそが研究の肝なんだなって本当に感じました。『キミおもい®』のペットへのやさしさの根源ってこれだなって、すごく大事なものを見せていただきましたね」(古坂さん)

学生が近づくとパドックから顔を出し、なでてと催促する馬のソフィア。「好かれてる~」(岡崎健志撮影)

学生とポジションを交代して、ソフィアをなでる。「あれ?耳が後ろに倒れちゃった。緊張してる?やっぱ俺じゃだめ?」とちょっぴり戸惑う古坂さんの後ろから、「ソフィアかわいいね、いつものかわいい顔!そう!」と学生がソフィアに声援を送っていた(岡崎健志撮影)
(取材・文/川本央子 企画制作/sippo編集部)
▼北里大学共同研究を紐解く 古坂大魔王さん来訪Part2 はこちら▼
-
ポレスター
-
-
-
-
-
-
-
-
浜松のスナフキン
-
-
ディズニー大好き
-
-
美味しい北日本
-
ブランウルス
-
-
-
-
-
けんたまま
-
-
たうるす
-
omochi
-
-
匿名希望
-
-
-
ぽっぽちゃんです。
-
-
-
-
-
DK
-
-
そうぱん
-
あくびちゃん紙製品はエリエール一択!ふわふわ優しいものが好きです。
-
-
-
ひつじとうさぎ
-
KoooJ
-
らっきー147
-
小菊
-
めぐ
-
さときち
-
まりまりま
-
-
-
ぺ天使
-
kyoro
-
-
-
-
はるちゃん。
-
ねこみみ
-
-
☆はるかぜ☆
-
-
えぬころ
-
はづ
-
ヒナヒナ
-
紫陽花の君
-
はりぃ
-
ちゅーちゃん
-
-
北乃虎吉
-
はるも
-
-
-
-
-
ホワイトホース
-
-
-
のんびりムーミン
-
maxboy
-
はつみさん
-
Roni
-
くりねずみ
-
はるうららこんにちは。 モニター応募とアンケート回答に励んでいます。 どうぞよろしくです。
-
-
苺大福
-
-
-
からあげとんこつ
-
-
あばばば
-
-
-
-
延
-
-
(退会者)
-
シャギ
-
ブール
-
-
-
-
-
-
シャンのおちり
-
-
-
ひーちゃんママ
-
-
-
-
えみこさん
-
ru-
-
ぴよ吉
-
皇帝ペンギン
-
-
-
saku
-
-
となりのアヒル
-
-
-
ジャンピー
-
コロっぺ
-
ミィーヤ
-
meg0601
-
べいま
-
-
-
サッポロナリ
-
-
-
ハピケイ
-
ペックル
-
-
きーゆさん
-
-
-
さいきん
-
-
-
papa
-
ぱっぱ
-
ダイン
-
-
ばにら3
-
-
エリエール婦人
-
-
ぷーさん7
-
-
チョコパフェ
-
-
けんまる
-
ミミ0530
-
-
たあさん
-
シグドン
-
-
デューク東郷
-
-
テルテル法師
-
-
ゆきべー
-
リコピン
-
-
-
-
-
-
-
あさちゃん
-
うっきい
-
-
プリン
-
山狸
-
-
-
あぶのニャンママ
-
ゆなつ
-
JOY
-
しろしろちゃん
-
猫のマリ
-
桜文鳥
-
アイス&あいす
-
-
イドゥ
-
-
おこめ
-
ぽんで
-
あっきー!
-
ひなちゃん
-
ぴろこ
-
ウラノス
-
-
ジェイムズ
-
水瀬由貴
-
いぬじ
-
そうす
-
-
-
aoba
-
-
(退会者)
-
-
キャボさん
-
-
でこちゃん
-
-
えーるね
-
-
-
りーさ
-
-
-
たー美よろしくお願いいたします。 エリエールいいですね!
-
すびん
-
-
-
-
-
-
ミソサザイ
-
さく@
-
-
じーちゃん
-
きいろ
-
t〜子よろしくお願いします。
-
笑門来福
-
-
-
-
-
yomogi
-
-
やもりお
-
しろぽん
-
ミカンっ子
-
ぴんくのうさぎ
-
なのはな
-
みもざ
-
むぎちゃんパパ
-
みみみーくん
-
viviv
-
-
-
どりさん
-
モルモット
-
こざくら
-
ururusydtor
-
万三郎
-
-
ショコラだよ!
-
-
-
まゆまゆゆんよろしくお願いします
-
なおちゃんこ
-
nomad
-
みきママmama
-
-
かずん
-
-
-
-
-
-
天使のたまご
-
ツンチ
-
六代目豆助よろしくお願いします。_(._.)_
-
0000
-
暴走天使
-
ショコラだよ
-
-
ゆんぽこ
-
-
うさポンとうさピイうさぎのポンタとピイです、仲良く遊んでます。
-
ちょこくっきー
-
くいしんぼ
-
Momo-G
-
-
たたたたあエリエール商品お肌に優しく大好きです♪
-
草取り名人
-
-
-
-
bluesky
-
kero
-
フルーツ
-
-
かぐや姫
-
Hirocchiよろしくお願いいたします。
-
-
-
かわっち
-
舞
-
インコのママさん
-
-




















